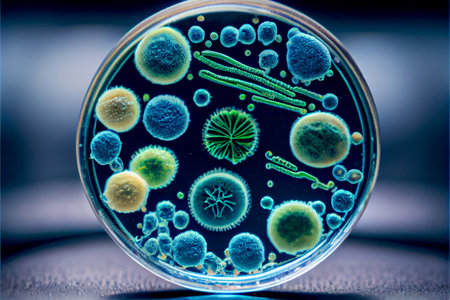
Close-up of virus cells or bacteria on light background. Virus background with disease cells and red blood cell. Corona virus outbreaking and Pandemic medical health risk concept.の素材

素材 - Close-up of virus cells or bacteria on light background. Virus background with disease cells and red blood cell. Corona virus outbreaking and Pandemic medical health risk concept.
作品情報
Close-up of virus cells or bacteria on light background. Virus background with disease cells and red blood cell. Corona virus outbreaking and Pandemic medical health risk concept.
- ID:211677422
- 作品種別:
- 作者名:imaginariumphoto
キーワード
- 3d render
- 3d rendering
- background
- bacterial infection
- biology
- concept
- contagious
- corona
- corona virus
- coronavirus
- covid-19
- danger
- diagnosis
- disease
- epidemic
- fever
- flu
- health
- health risk
- human influenza
- illness
- illustration
- immunity
- infect
- infection
- influenza
- lethal
- medical
- microbe
- microbiology
- microscopic
- new strain
- pandemic
- pathogen
- pathogenic
- pathology
- pneumonia
- prevention
- science
- sickness
- superbug
- symptoms
- treatment
- vaccine
- viral
- virology
- virus
類似作品
Abstract geomet...
Minimalistic 3d...
Coronavirus COV...
Microscopic Vie...
Detailed visual...
Dangerous Pande...
a close-up port...
Microscopic per...
3D illustration...
Viruses in infe...
Coronavirus cel...
Dangerous Pande...
Coronavirus inf...
Concept of COVI...
virus particles...
A close up view...
Advanced lab se...
Virus illustrat...
Abstract illust...
Coronavirus cel...
Colorful displa...
Epidemiology co...
Shield protecti...
Coronavirus 201...
Minimalistic 3d...
Coronavirus COV...
Chinese pathoge...
3D Illustration...
Microscopic vie...
Virus infected ...
Realistic 3D mo...
Virus, pathogen...
Virus on dark b...